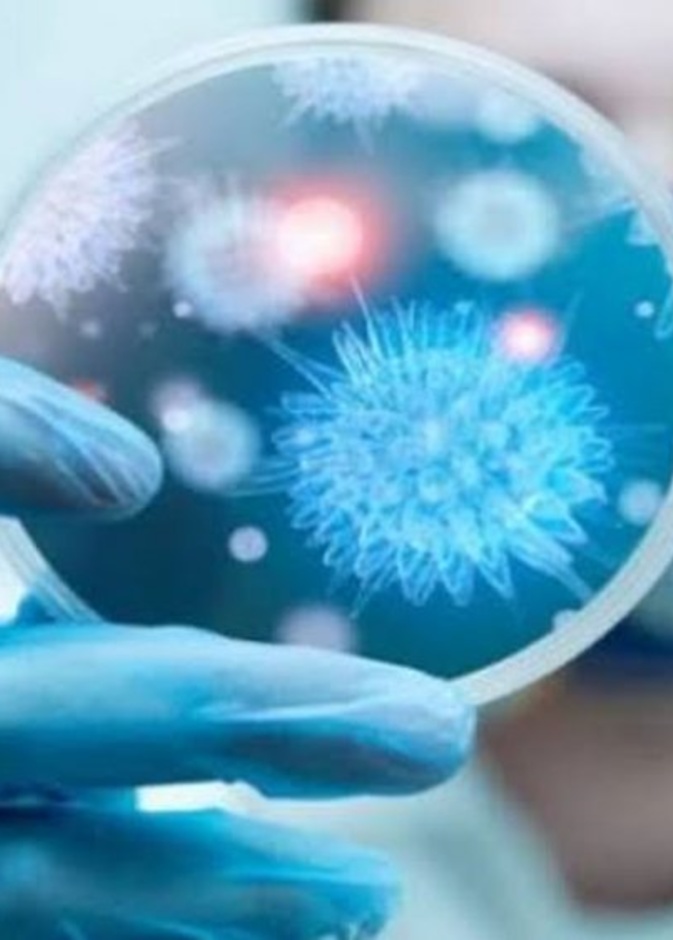
مرضى الأمراض الدماغية أكثر عرضة لفيروس كورونا

تأثير الحالة النفسية على الوزن كبير ولافت، فكثير من المشاهير أكدوا أن زيادة وزنهم كانت نتيجة مشاكل نفسية مروا بها
صحة ورشاقة
صحة ورشاقة
آلام أسفل الظهر، أسبابها وطرق علاجها نتعرف عليها في مقابلة "هي" مع الدكتور رضا طلبة من مستشفى كليفلاند كلينك أبوظبي. كما يتطرق الحديث لتقنية "إنتراسبت™" التي تُعدَ علاجاً مبتكراً طفيف التوغل لآلالم أسفل الظهر المزمنة
فوائد اوميجا 3 بلس للجسم واضرار الافراط فيه من المهم التعرف عليها فهي من الأحماض الدهنية وأحد العناصر الحيوية جداً و الجسم لا يقوم بإنتاجها
من هم اكثر الاشخاص عرضة للاصابة بفيروس كورونا الجديد هم الأشخاص الذين يعانون من أمراض القلب و الأمراض الوعائية و الأمراض الدماغية ومرضى السكري